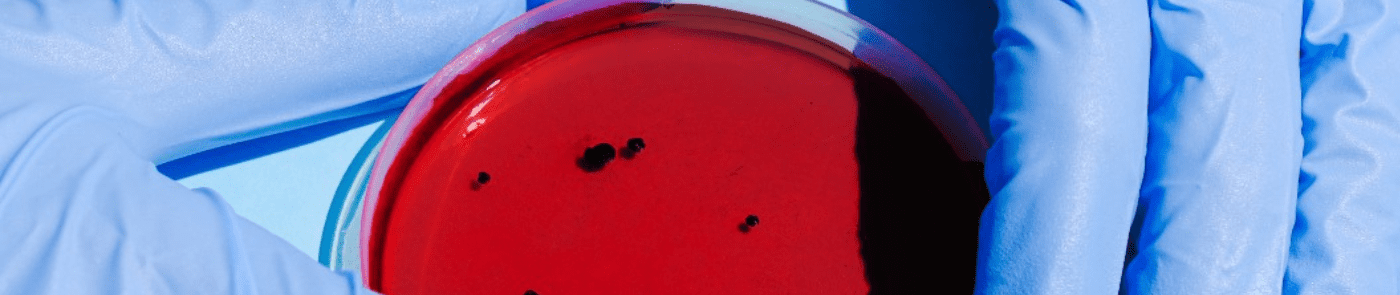
Medical Device Sterilization

Issues related to Medical Device Sterilization in the era of multi-drug resistant Bacteria
With the emergence of multi-drug resistant bacteria, medical device sterilization has become a critical issue. Some of the main issues related to medical device sterilization in the era of multi-drug resistant bacteria include:
1. Inadequate sterilization: Multi-drug resistant bacteria are often resistant to traditional sterilization methods, such as heat and chemical sterilization. This can result in inadequate sterilization of medical devices, leading to the potential for infection transmission.
2. Cross-contamination: Multi-drug resistant bacteria can survive on medical devices and can be transmitted from one patient to another if the devices are not properly sterilized between uses. This can lead to the spread of infections in healthcare facilities.
3. Increased risk for patients: Patients who are already immunocompromised or have underlying health conditions are at increased risk for infections from multi-drug resistant bacteria. The use of contaminated medical devices can further increase their risk for infections.
4. Limited treatment options: Multi-drug resistant bacteria are often resistant to multiple classes of antibiotics, which can limit treatment options for infected patients. This can lead to longer hospital stays, higher healthcare costs, and increased mortality rates.
5. Regulatory challenges: Regulatory agencies, such as the FDA, have increased their scrutiny of medical device sterilization processes in response to the emergence of multi-drug resistant bacteria. This has led to increased regulatory challenges for medical device manufacturers, who must demonstrate the effectiveness of their sterilization processes.
Addressing the issues related to medical device sterilization in the era of multi-drug resistant bacteria requires a multi-faceted approach. Some potential strategies include:
1. Improved sterilization methods: Research is ongoing to develop new sterilization methods that are effective against multi-drug resistant bacteria. For example, some studies have shown that using hydrogen peroxide vapor or ultraviolet light can be effective against these bacteria. Steril Medipac is one of the leading Indian manufacturers of packaging of new sterilization methods offering rolls, sterilization reels and pouches suitable for hydrogen peroxide vapor sterilization.
2. Enhanced cleaning protocols: Proper cleaning of medical devices before sterilization is crucial to prevent the transmission of multi-drug resistant bacteria. Healthcare facilities should implement enhanced cleaning protocols for medical devices, including the use of high-level disinfectants and detergents.
3. Increased awareness and education: Healthcare providers and patients should be educated about the risks associated with multi-drug resistant bacteria and the importance of proper sterilization of medical devices. This can help to increase awareness and promote adherence to proper sterilization protocols.
4. Improved surveillance and monitoring: Healthcare facilities should implement surveillance and monitoring programs to track the incidence of multi-drug resistant bacteria and identify any potential outbreaks. This can help to identify areas for improvement in sterilization processes and prevent the spread of infections.
5. Collaboration and innovation: Collaboration among healthcare providers, researchers, and medical device manufacturers is crucial to address the challenges of medical device sterilization in the era of multi-drug resistant bacteria. Innovation in sterilization methods and technology can help to improve the effectiveness of sterilization processes and reduce the risk of infection transmission.
In conclusion, medical packaging device sterilization in the era of multi-drug resistant bacteria is a critical issue that requires a multi-faceted approach to address. Inadequate sterilization, cross-contamination, increased risk for patients, limited treatment options, and regulatory challenges are some of the main issues related to medical device sterilization in the era of multi-drug resistant bacteria. Strategies to address these issues include improved sterilization methods, enhanced cleaning protocols, increased awareness and education, improved surveillance and monitoring, and collaboration and innovation. By implementing these strategies, healthcare facilities can help to reduce the risk of infection transmission and improve patient outcomes.